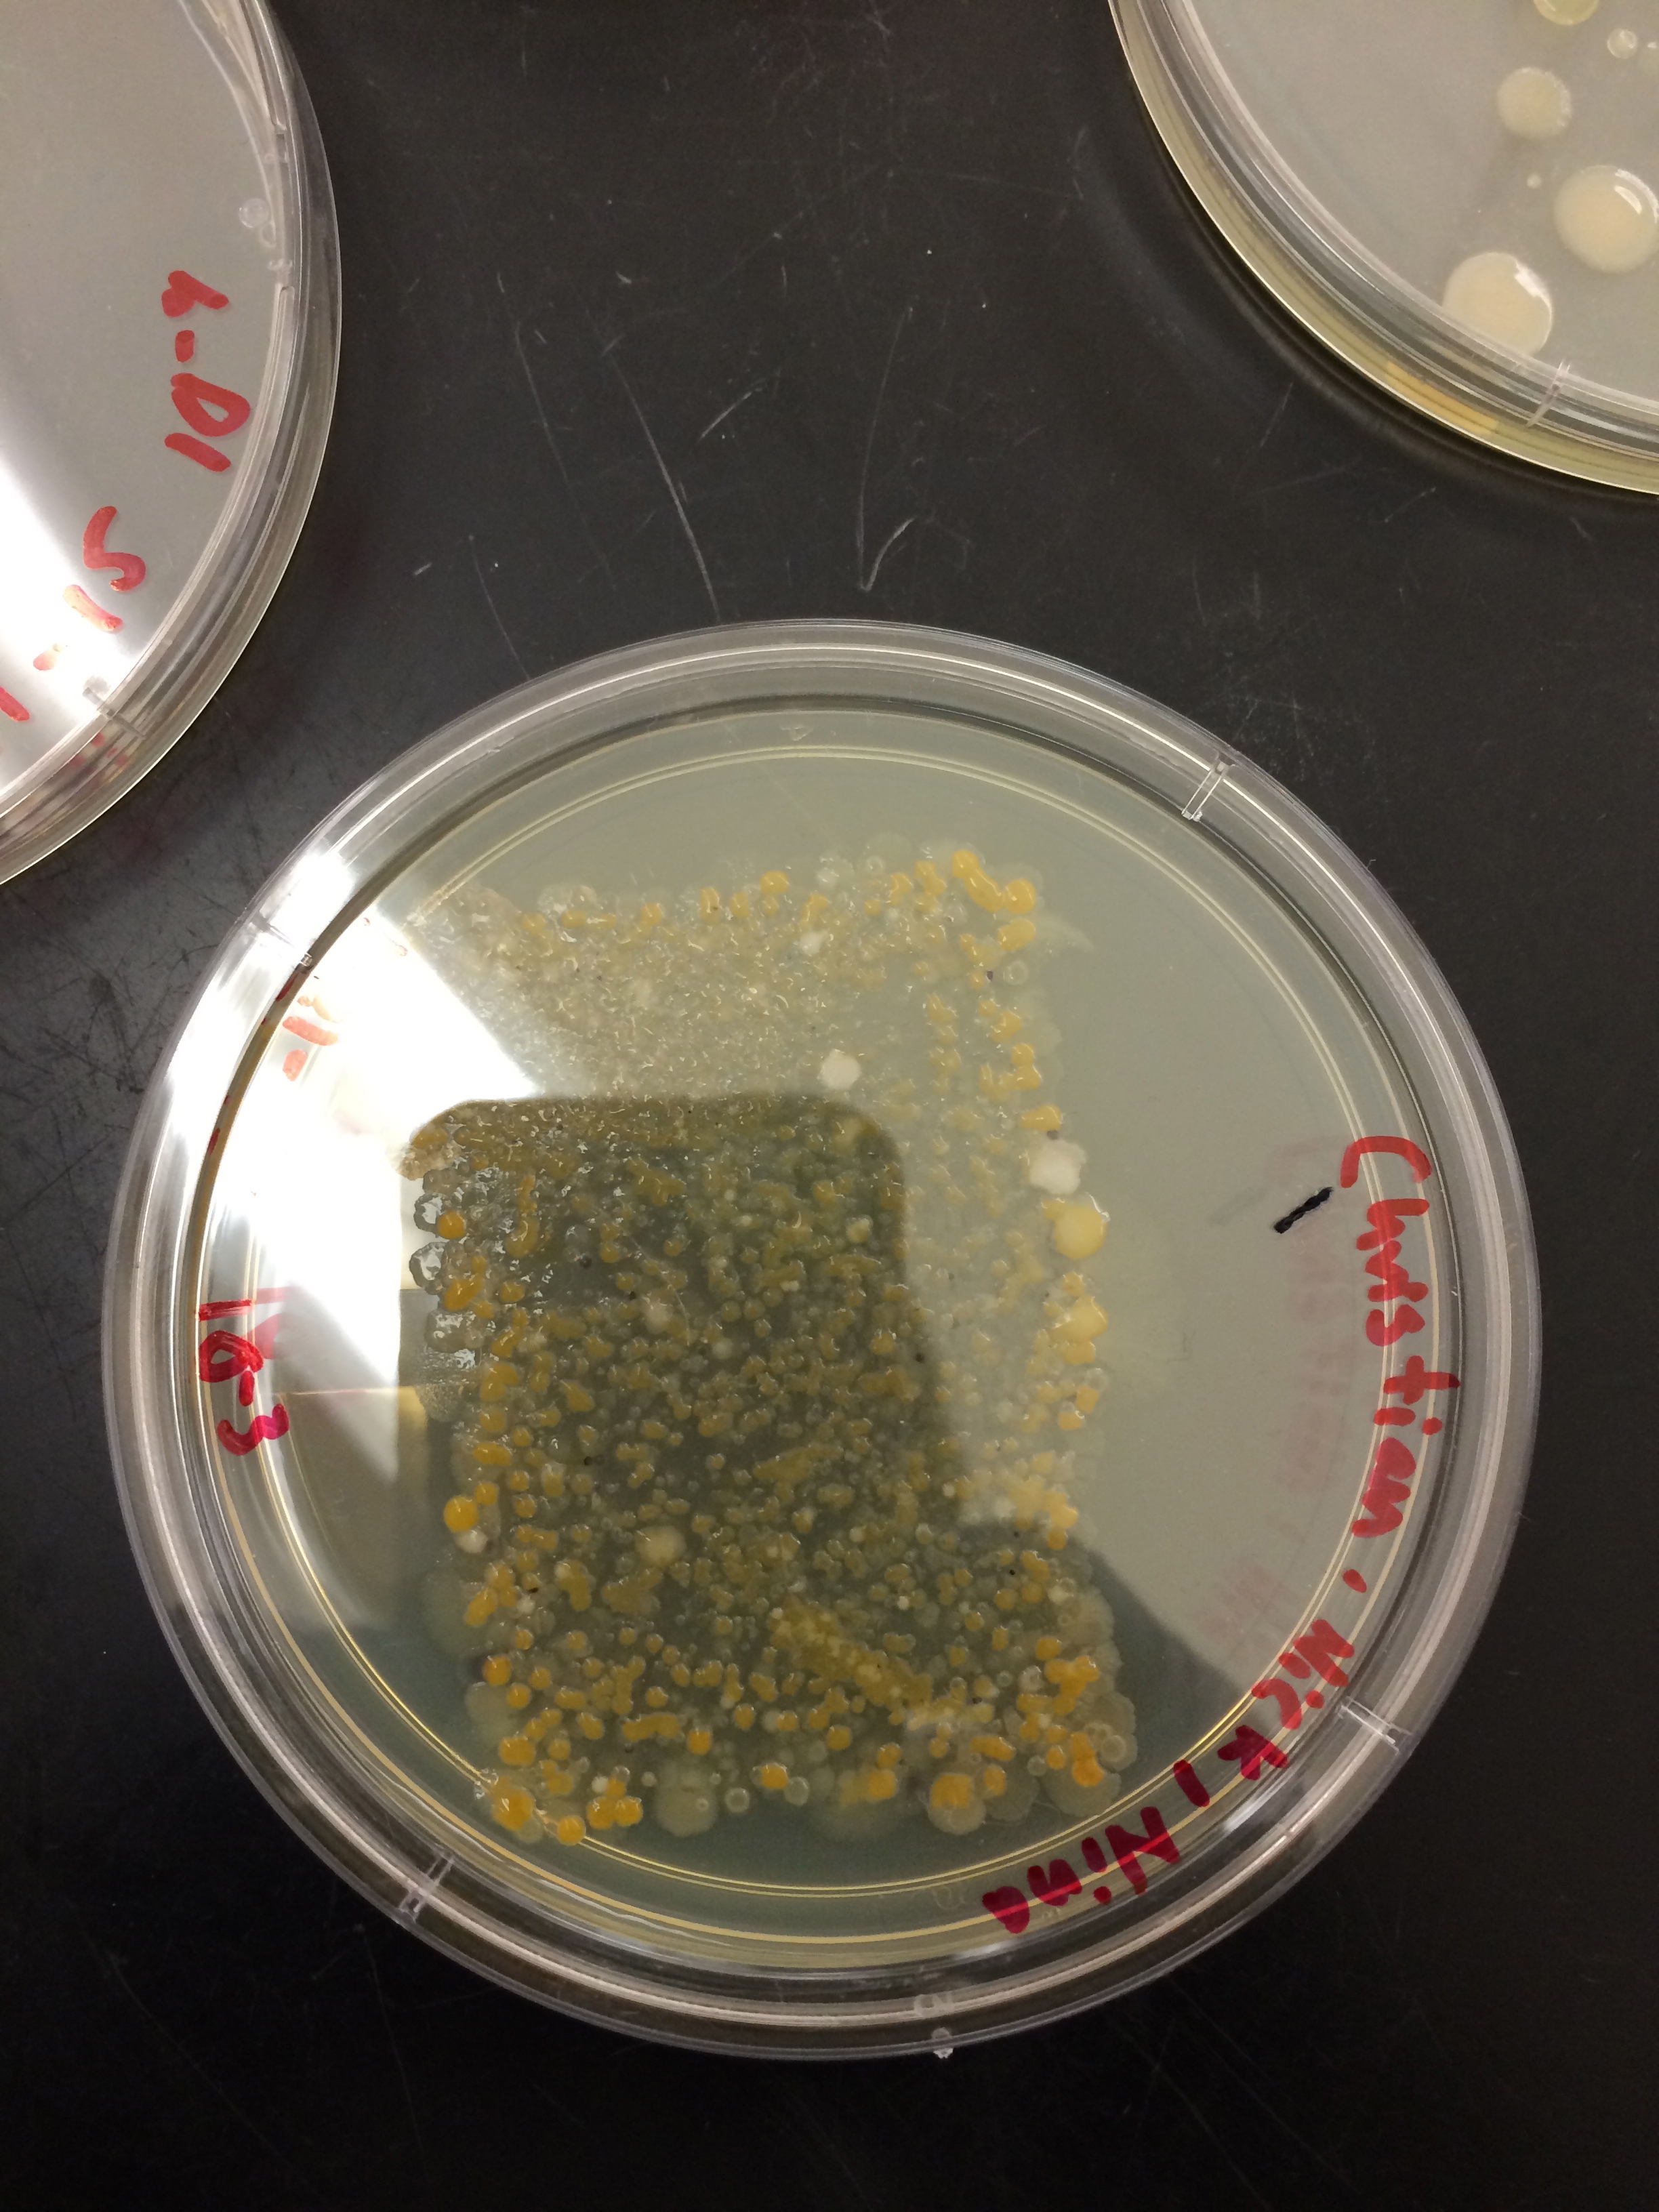
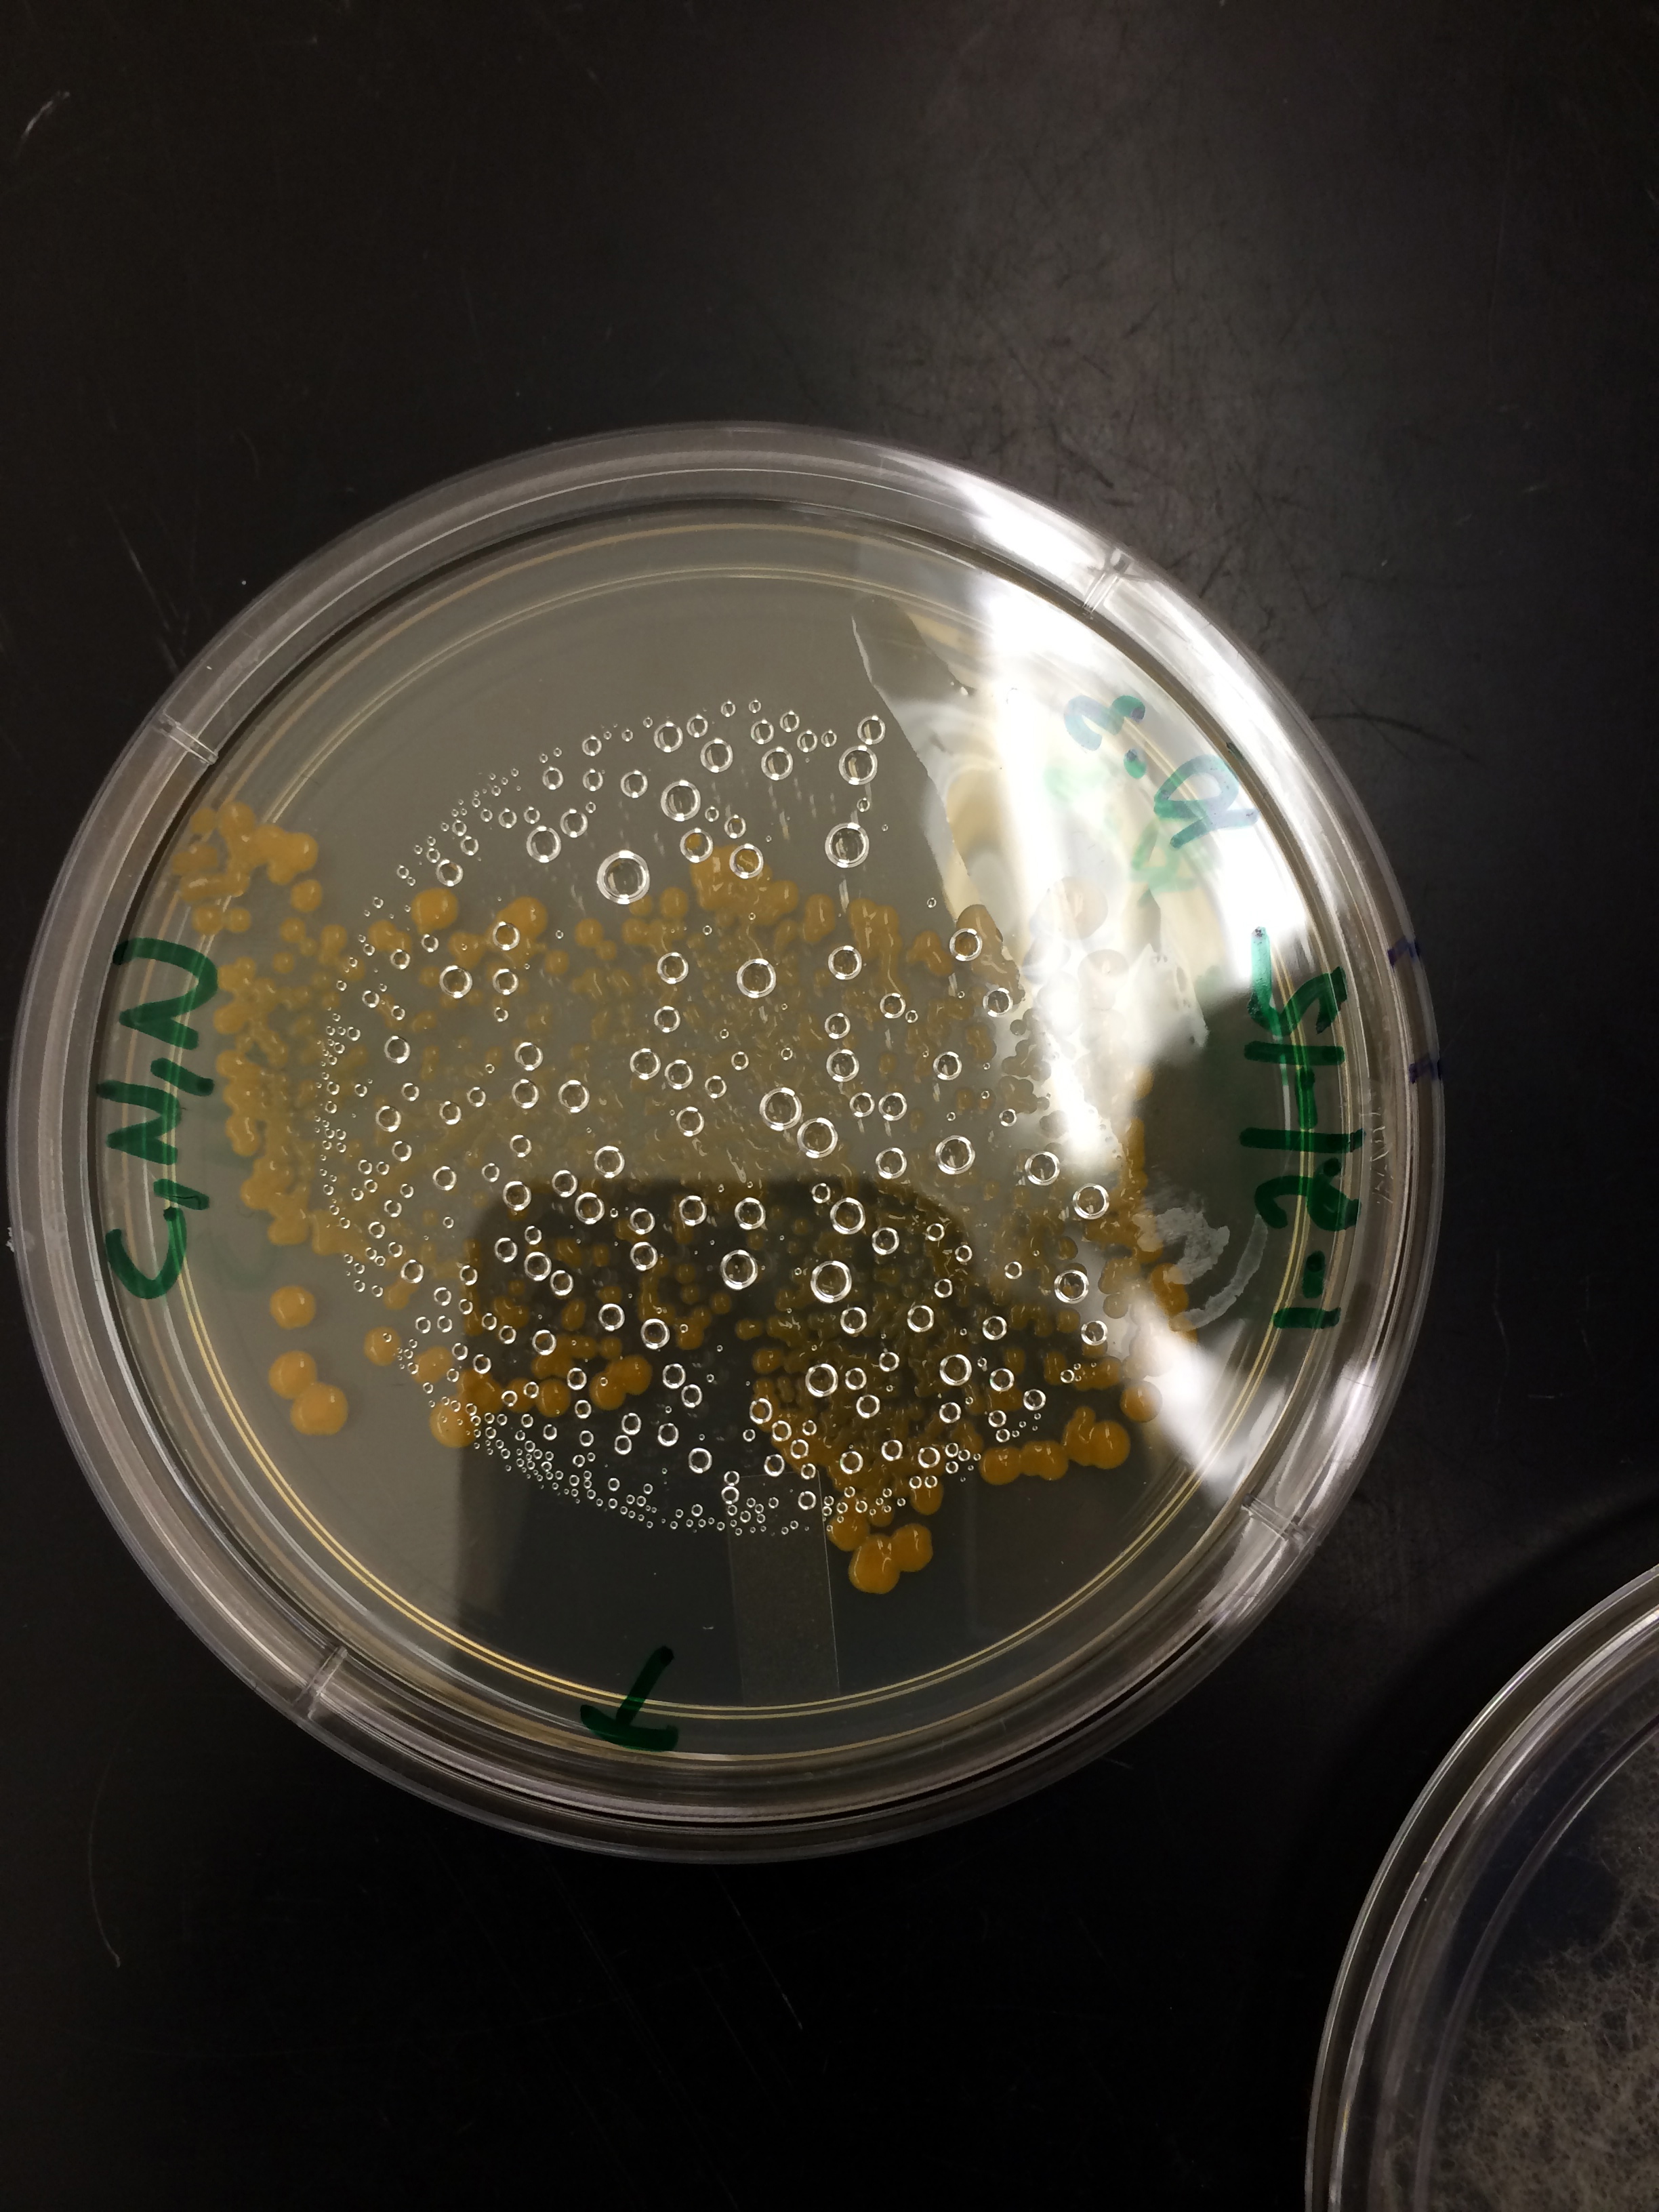

User:Nina Bocchini/Notebook/Biology 210 at AU
2/18/15- NB
Invertebrates
The objective of this lab was to understand the importance of invertebrates. The world of invertebrates is highly diverse with 14 different phyla of organisms. The second objective of the lab was to learn simple systems and how they evolved into more complex systems. We looked at the soil invertebrates from our transect. Most soil invertebrates are Arthropods, this phyla includes both adult insects and their larvae.
The first step of the lab was to take apart the Berlese Funnel and pour the top fluids of the liquid and organisms into a petri dish. Then we poured the remaining liquid and organisms into another petri dish. Then we examined 5 organisms under a dissecting microscope. Then we identified the class of the arthropoda invertebrates we saw. We looked at a key from the website hope.edu.
The first organism we found was a Collembola Arthropoda. It was 3mm long and we found one in our sample. It was found in the top of the tube from the Berlese Funnel. It had 6 legs and a short body. The second organism was from the Arthpoda phyla and a termite. It was 1 mm long and we only found one. It was so small it was hard to tell much more about what it looked like. The third organism was from the Nematoda phylum and it was an unsegment worm. It was 3 mm long and we found 2 from the bottom. It was a long white sliver and skinny. The fourth organism was Annelida and it was a segmented worm. It was .5 mm long and we only found one in the bottom. It had a red line through the middle. The last organism we observed was a Arthopoda. An thysanura or Diplua. It was a lot bigger than the others. It was 6 mm long and from the bottom. We only found one. This one had six legs and a big body. It also had antennas and a short tail.
Most of our organisms were from the bottom of the tube. Also the three out of the five organisms found were from the Anthropoda phyla. This means that our transect is favorable to soil invertebrates. The fact that we couldn’t find that many invertebrates means that our transect is not a good place for them to live. Maybe because it is so well groomed by humans, invertebrates don’t thrive there.
The five vertebrates that could live in my transect are robins, mice, rats, squirrels, and hawks. The robin is in the phylum chordate and class is Aves. The biotic characteristics are bushes and the abiotic are the temperature and transect layout. The mice are chordate and Mammalia. The biotic characteristics are the long grass, insects and bushes. The rats are also from the chordate phylum and the class is Mammalia. The biotic characteristics are long grass and insects. The abiotic are human trash, and the layout of the transect. Squirrels are also from the chordate and are in the Mammalia class. The biotic characteristics are the rose bushes and insects. The abiotic are trash from humans and the layout of the transect. The last possible vertebrate is the hawk and it is from the chordate phylum and the Aves class. The biotic characteristics are the mice and rats. The abiotic are the open landscape and the cut grass.
2/10/2015 - NB
Plantae and Fungi
The objective of this lab is to understand the characteristics and diversity of plants. It is also to gain an appreciation for the function and importance of Fungi. In this lab we identified the characteristics of a Bryophyte moss and angiosperm. Then we looked at five plants from our transect. The differences in the vasculature between the Bryophytes and Angiosperms provide examples of increased cell differentiation and specializations in plants. Examining leafs also helps determine differences between the two.
The first step of the lab was to collect 5 plants and leaf litter from the transect. It was important to pick plants that were diverse. Then we characterized the vascularization in each of the 5 plants that we collected. We wrote down the height and then we prepared and observed a cross section from each plant. Our group also took note of the plants shape, size, and cluster arrangement of the leaves. If it didn’t have leaves we looked at the attachment sites of leaves. Then we set up a Berlese Funnel to collect invertebrates from the leaf little collected from the transect. We also observed different types of fungi and decided which group they belong to. The last thing we did was observed the PCR we started last lab.
Leaf Litter and the Berlese Funnel


The five plants we collected were a rose bush stem, long grass from under the rose bush, a bush cut down to stems, short grass, and a bulb. There are 5 rose bushes in our transect and it was located of the west side of our transect. The rose bush branch is 15 cm long. The vascularization is dicots and stem like. It has vascular bundles that are usually arranged in a ring. The specialized structures are peduncle, receptacle, pistil, and sepal. It reproduces through seeds. The long grass was found under the rose bushes and there was around 10 bushels. It’s green and about 24 cm long from root to tip. The vascularization is monocot and it has veins that are usually arranged in parallel lines. The specialized structure is sepal and it reproduces from roots. The cut bush was located near the man made sign at the north side of our transect and there was only one bush. It’s a brown skinny branch with roots on one side. It’s about 18 cm long and the vascularization system is Fibrous and it has a root system. We could not see any specialized structures but it reproduces through roots. The short grass is what makes up most of our transect. It’s green, short, skinny, and about 4 cm long. The roots are brown and white. The vascularization of the grass is monocots with a leaf venation. The veins are usually parallel and the specialized structure is the peduncle and the method of reproduction is seeds and roots. The last plant we looked at was the bulb we found next to the rose bush of the north side of the transect. There were about 5 bulbs visible. The bulb is short, purple, white, green, circular, and it has a green stem sprouting out of the top. It’s about 10 cm tall. The vascularization is a fibrous root system and it has monocot roots. The specialized structures are the root tips and the bulb itself. It also reproduces through bulbs.
The rose bush location and picture


The grass location and picture


The cut bush location and picture


After observing the five plants from my group’s transect we found that most of our plants had a root system of reproduction. Also most of our plants that were grass like had a leaf venation of parallel veins. Another interesting finding is that most of our plants were monocots. Then we took a look at the fungi. Fungi sporangia are spores that are black and are nicknamed the black bread mold. The spores release when the sporangia open. The fungi observed fit into three categories. The mushroom fit into the Basidiomycota lineage. The slide with Rhizopus nigricans, sporangia is part of the zygomycota lineage. The last slide I looked at was the Focus male and female conceptacle sec. This slide fits into the Ascomycota lineage.
Focus male and female conceptacle sec.

February 3, 2015- NB
Microbiology and Identifying Bacteria with DNA Sequences
The objective of this lab was to understand characteristics of bacteria. Another aspect of the lab was to look at antibiotic resistance and to understand how DNA sequences are used to identify species. We looked at the agar plates that we made the week before to see the bacteria that grew. We could tell that the bacterium was not going to be a Archaea species because they live in really hot places.
The first step we took was to look at the Hay Infusion Culture we made in the lab. The Hay Infusion changed in texture and turned a lighter brown because the organisms inside had a longer time to grow and we had shaken the jar so it disrupted the ecosystem. Then we observed the growth on the agar plates from the past week. We counted the total number of colonies that developed on the plates. After that we looked at prepared slides of bacteria and then observed a native wet mount preparation and a gram stain of two colonies from the nutrient agar plate and two from the tetracycline plate.
When looking at the colonies that developed on the agar plates when the dilution is 10^-3 on the nutrient agar plate the colonies counted were 200. The colonies were small, flat, and a light orange color. When the dilution for the 10^-5 on the nutrient agar plate 57 colonies grew. The colonies were small, flat and white. When the dilution is 10^-7 on the nutrient there was only one colony and there was none when the dilution was 10^-9. For the nutrient and tetracycline agar plates when the dilution was 10^-3 150 colonies grew and they were big, raised and orange. They were also coccus shaped. When the dilution was 10^-5 the number of colonies the developed was 22 and the colonies were small, flat, and orange. When the dilution was 10^-7 only one colony grew and when it was 10^-9 no colonies grew. After looking at the native wet mount of the nutrient 10^-3 we saw that the cells had no motility, were arranged in a line, and were shaped like streptococci. Then we looked at the native wet mount from the nutrient and tetracycline agar plates and saw that the cells had no motility, had no arrangement and were shaped like streptococci. Then we looked at the gram stain we found that the nutrient 10^-3 was gram positive. The nutrient 10^-5 was also gram positive. The nutrient and tetracycline 10^-3 was gram negative and the 10^-5 was gram negative.
Hay Infusion Culture
 Nutrient 10^-3
Nutrient 10^-3
Nutrient 10^-5
Nutrient 10^-5
 Nutrient and tet 10^-3
Nutrient and tet 10^-3
Nutrient and tet 10^-5
Nutrient and tet 10^-5
 Nutrient 10^-3 wet mount
Nutrient 10^-3 wet mount
 Nutrient and tet 10^-3 wet mount
Nutrient and tet 10^-3 wet mount
 N 10^-3 gram stain
N 10^-3 gram stain
 T 10^-5 gram stain
T 10^-5 gram stain
 N 10^-5 gram stain
N 10^-5 gram stain
 T 10^-3 gram stain
T 10^-3 gram stain

I noticed that when the plates had the antibiotic on it y had a smaller number of colonies. The cell arrangement was also different; the plate with just the nutrient was arranged in a line while the plate with the antibiotic on it was randomly arranged. The antibiotic plates were gram negative while the nutrient plates were gram positive. The tetracycline made it harder for the bacteria to grow and organize itself into arrangements. All the bacteria we looked at in our plates were affected by the tetracycline. Tetracycline were discovered in 1940’s and exhibited activity against a wide range of microorganisms including gram-positive and gram-negative bacteria, chlamydia, mycoplasmas, rickettsiae, and protozoan parasites. But there are bacteria that have become resistant to tetracycline like shigella dysenteria. The resistance to tetracycline is growing and this could limit the use of these agents in treatment for disease.
Chopra, I., & Roberts, M. (2001). Tetracycline Antibiotics: Mode of Action, Applications, Molecular Biology, and Epidemiology of Bacterial Resistance.Microbiology and Molecular Biology Reviews, 62(2), 232-260. Retrieved February 4, 2015, from US National Library of Medicine National Institutes of Health.
1/28/2015 – NB
Lab 2- Identifying Algae and Protists
In this lab we identified the unicellular eukaryotic organisms in the Hay Infusion Culture we made in the lab before. The goal of this lab was to learn how to identify and classify these organisms by learning to use a dichotomous key. It also let us observe protists and algae to see that they are different because protists do not complete photosynthesis. Each group took two samples from the top and the bottom of the Hay Infusion Culture. This was to display that within one ecosystem there can be multiple niches.
Before we started we smelled the culture and noticed that it smelled like dirt. We also saw that there was brown mold and white specks on the top. Then we took two samples from the top of the ecosystem and from the bottom because the organisms growing on the bottom and on the top can be different. After taking the samples we made a wet mount of the top and the bottom. Then we observed the wet mounts in a microscope and found three protists from the top and three protists from the bottom. The we determined what protists were present using the dichotomous key. One we determined what the protists were we drew them in our lab note books.
We found three organisms from the top and they were the Paramecium Multimicroucleatum, Paramecium Bursria, and the Euplotes sp. From the bottom sample we found the Paramecium Aurelia, Colpidium, and the Paramecium sp. All of our organisms were motile.
Two out of the three organisms on the bottom and the top were a type of paramecium. Paramecium have cilia for motility and these organisms had visible cilia for mobility, this was one of the signs of the key that they were paramecium. It is important to note that paramecium belong to the Ciliates group and are part of the Alveolata lineage. This is evidence that might prove that our ecosystem is part of the Alveolata lineage. If the Hay Infusion Culture grew for two more months I think the Paramecium Multimicroucleatum would dominate the top because it is the biggest and seems to thrive in these ecosystem. The biggest pressure of the ecosystem would be it's limited space and resources.
January 26, 2014 – NB
Lab 1 : Biological Life at AU
The purpose of this lab was to understand natural selection and understand biotic and abiotic characteristics of a niche. We are looking at three different algae families in order to understand natural selection. The families we looked at were Chlamydomonas, Gonium, and Volvox. We first observed the isogamous, unicellar, motile alga that is found in damp soil, lakes, and ditches and it is called Chlamydomas. Then we looked and the Gonium, which is more complex species that consists of colony of multiple cells. Lastly we looked at the Volvox and it has thousands of spiked cells. This represented the peak of evolutionary complexity in the volvocine line.
We looked at our transect and determined what type of ecological system it might be and to see interactions that are typical of the community inhabiting different niches in an ecosystem. The transect my group was given was in the middle of the quad, on the outskirts of the stone circle. It was mostly manicured grass but there were some bushes and part of a man made stone sign in it. The abiotic components of the transect were bushes, grass, leafs, branches, and flower bushes. The biotic components of the transect were dirt, snow, and the stone sign.
Once my group had drawn the transect and determined what was biotic and abiotic, we took a soil sample that would be used to represent the transect. Then we went back to the lab and made a Hay Infusion Culture. We did this in order to observe protest and to inoculate agar petri plates for studying bacteria at a later date.
After observing the transect we determined that the area was a manicured landscape. It is completely groomed and taken care of by man. So the organisms in the transect had to adapt to the ecosystem that is altered by man in order to survive.
test AP













